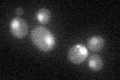
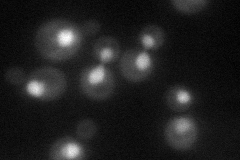
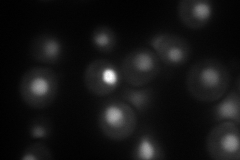
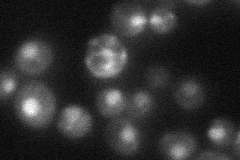
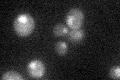

View description
Protein of unknown function; gene expression increases in cultures shifted to a lower temperature
Localization:
Intensity:
Fold change:
Significance:
-
C’ GFP library in SD
nucleus29.61 -
N' NOP1pr-GFP in SD
nucleus95.6909 -
N' TEF2pr-mCherry in SD
nucleus101.88 -
N' NATIVEpr-GFP in SD
nucleus40.2517 -
N' TEF2pr-VC and Cyto-VN in SD

nucleus44.8415 -
C’ GFP library in SD+DTT

nucleus28.240.95No -
C’ GFP library in SD+H2O2

nucleus29.160.98No -
C’ GFP library in Starvation Media
nucleus23.590.79No -
C’ GFP library on the background of Pup2-DaMP

nucleus -
C’ GFP library on the background of CCT mutant

nucleus28.32010.95627No
